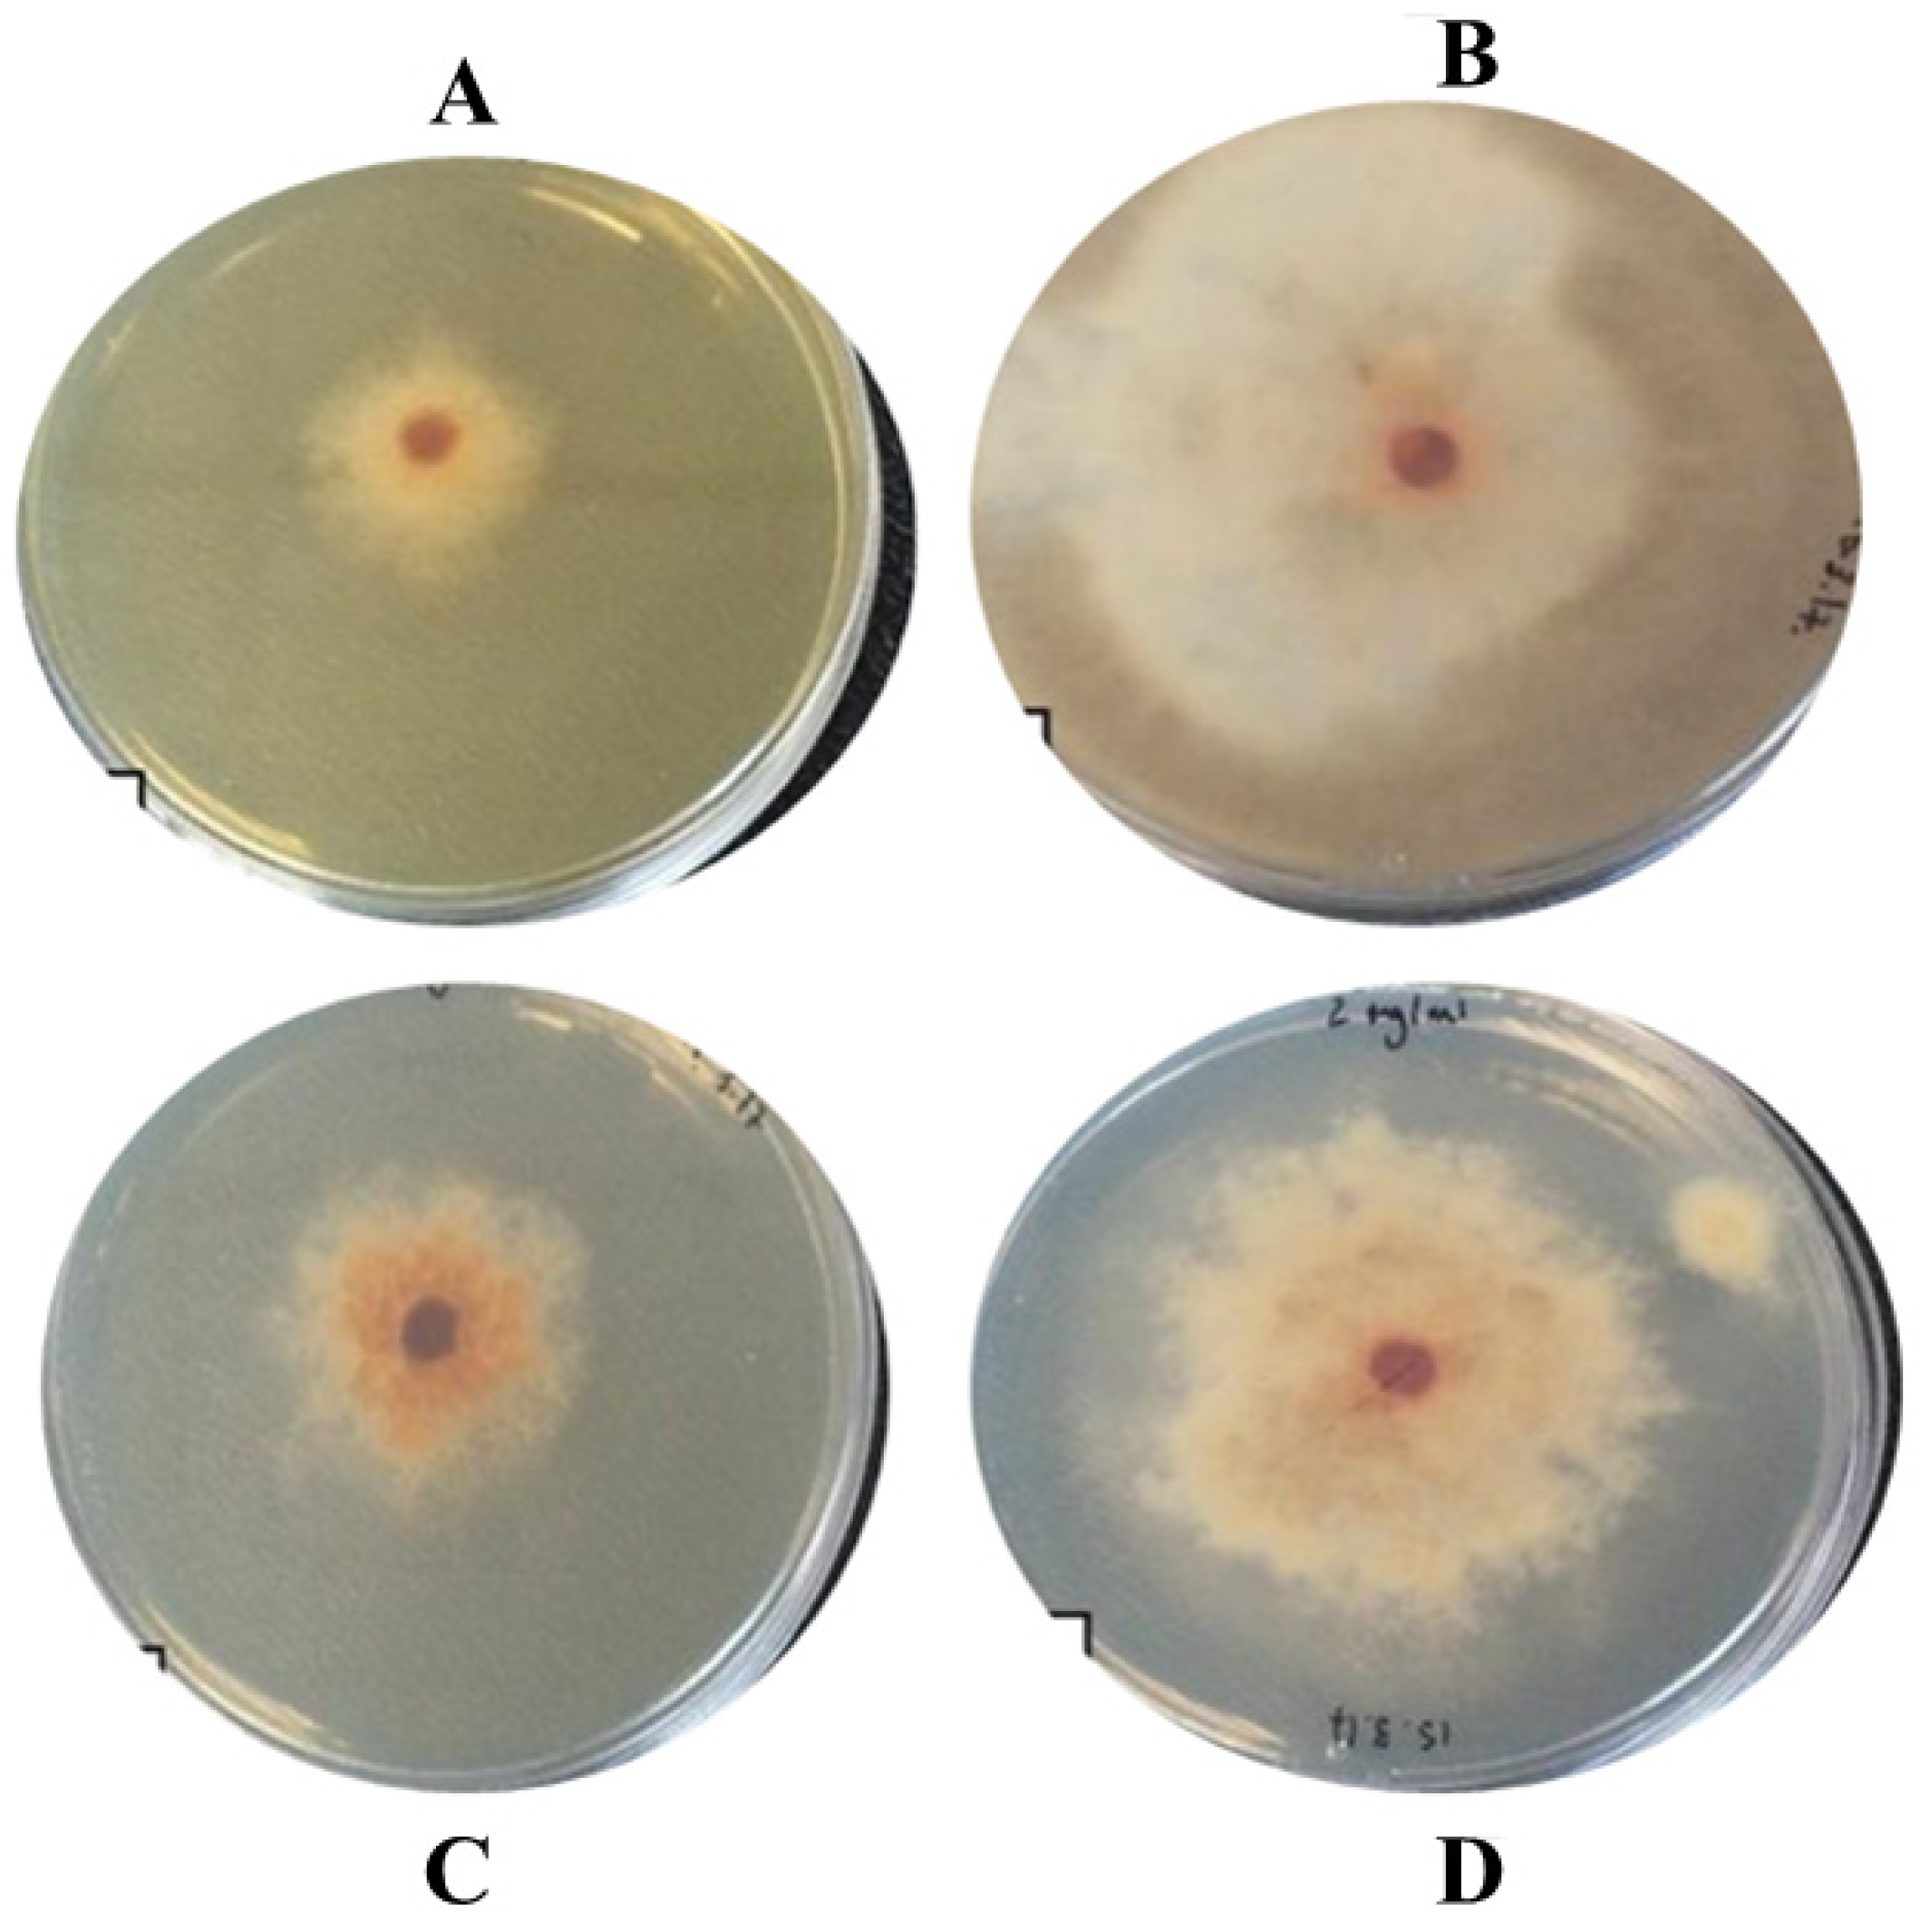
Catalysts 12 00558 g007 550

Fagonia cretica-Mediated Synthesis of Manganese Oxide (MnO2) Nanomaterials Their Characterization and Evaluation of Their Bio-Catalytic and Enzyme Inhibition Potential for Maintaining Flavor and Texture in Apples
Abstract
:1. Introduction
2. Results
2.1. Synthesis Mechanism
2.2. Characterization
2.3. Anti-Browning Activity of NPs
2.3.1. Tyrosinase Assay
2.3.2. Antioxidant Assay
2.3.3. Anti-Spoil Activity of NPs against Spoil-Causing Fungal Isolate Species
3. Discussion
4. Materials and Methods
4.1. Chemicals
4.2. Collection of the Plant Material
4.3. Preparation of Leaves Extract of Fagonia cretica
4.4. Biogenic Synthesis of Manganese Dioxide NPs (MnO2 NPs)
4.5. Characterization of Biosynthesized MnO2 NPs
4.6. Anti-Browning Activity of NPs
4.6.1. Tyrosinase Assay
4.6.2. Antioxidant Assay
4.7. Anti-Spoil Activity of NPs against Spoil-Causing Fungal Isolate Species
4.7.1. Sample Collection of Spoilt Apple
4.7.2. Culture Media Preparation
4.7.3. Isolation of Fungi from Spoilt Fruits
4.7.4. Identification of Fungal Isolates
4.8. Antifungal Activity
5. Conclusions
Author Contributions
Funding
Data Availability Statement
Conflicts of Interest
References
- Muk, M.F.; Wu, N.R.; Danl, U.I.; Salisu, N. Isolation and characterization of fungal species from spoilt fruits in Utako market, Abuja, Nigeria. J. Appl. Sci. 2018, 19, 15–19. [Google Scholar] [CrossRef]
- Anand, S.P.; Sati, N. Artificial preservatives and their harmful effects: Looking toward nature for safer alternatives. Int. J. Pharm. Sci. Res. 2013, 4, 2496. [Google Scholar]
- Kumbi, Y. Phytochemical Characterization of Fagonia Indica and its Effects on MCF-7 Breast Cancer Cell Line. 2019. Available online: https://ir.library.oregonstate.edu/downloads/cj82kd531 (accessed on 14 April 2022).
- Pillaiyar, T.; Manickam, M.; Namasivayam, V. Skin whitening agents: Medicinal chemistry perspective of tyrosinase inhibitors. J. Enzym. Inhib. Med. Chem. 2017, 32, 403–425. [Google Scholar] [CrossRef] [PubMed] [Green Version]
- Basavegowda, N.; Idhayadhulla, A.; Lee, R.Y. Tyrosinase inhibitory activity of silver nanoparticles treated with Hoveniadulcisfruit extract: An in-vitro study. Mater. Lett. 2014, 129, 28–30. [Google Scholar] [CrossRef]
- Abbas, Q.; Saleem, M.; Phull, A.R.; Rafiq, M.; Hassan, M.; Seo, K.L.S. Green synthesis of silver nanoparticles using bidensfrondosaextract and their tyrosinase activity. Iran. J. Pharm. Res. 2017, 16, 763–770. [Google Scholar]
- Faisal, S.; Jan, H.; Abdullah; Alam, I.; Rizwan, M.; Hussain, Z.; Sultana, K.; Ali, Z.; Uddin, M.N.U.M.N. In Vivo Analgesic, Anti-Inflammatory, and Anti-Diabetic Screening of Bacopa monnieri-Synthesized Copper Oxide Nanoparticles. ACS Omega 2022, 7, 4071–4082. [Google Scholar] [CrossRef]
- Faisal, S.; Abdullah; Rizwan, M.; Ullah, R.; Alotaibi, A.; Khattak, A.; Bibi, N.; Idrees, M. Paraclostridium benzoelyticum Bacterium-Mediated Zinc Oxide Nanoparticles and Their In Vivo Multiple Biological Applications. Oxid. Med. Cell. Longev. 2022, 2022, 5994033. [Google Scholar] [CrossRef]
- Sabir, M.S.; Rajendra, C.D.; Amol, S.; Poournima, S.S. A review on: Preservatives used in pharmaceuticals and impacts on health. PharmaTutor 2016, 4, 25–32. [Google Scholar]
- Moon, S.A.; Salunke, B.K.; Alkotaini, B.; Sathiyamoorthi, E.; Kim, B.S. Biological synthesis of manganese dioxide nanoparticles by Kalopanax pictus plant extract. IET Nanobiotechnol. 2015, 9, 220–225. [Google Scholar] [CrossRef]
- Prasad, K.S.; Patra, A. Green synthesis of MnO2 nanorods using Phyllanthus amarus plant extract and their fluorescence studies. Green Process. Synth. 2017, 6, 549–554. [Google Scholar] [CrossRef]
- Lu, H.; Zhang, X.; Khan, S.A.; Li, W.; Wan, L. Biogenic synthesis of MnO2 Nanoparticles with leaf extract of Viola betonicifolia for enhanced antioxidant, antimicrobial, cytotoxic, and biocompatible applications. Front. Microbiol. 2021, 12, 3329. [Google Scholar] [CrossRef] [PubMed]
- Selvaraj, K.; Daoud, A.; Alarifi, S.; Idhayadhulla, A. Tel-Cu-NPs catalyst: Synthesis of naphtho [2, 3-g] phthalazine derivatives as potential inhibiters of tyrosinase enzymes and their investigation in kinetic, molecular docking, and cytotoxicity studies. Catalysts 2020, 10, 1442. [Google Scholar] [CrossRef]
- Mahlangeni, N.T.; Moodley, R. Biosynthesis of manganese oxide nanoparticles using Urginea sanguinea and their effects on cytotoxicity and antioxidant activity. Adv. Nat. Sci. Nanosci. Nanotechnol. 2021, 12, 015015. [Google Scholar] [CrossRef]
- Thirumurugan, A.; Ramachandran, S.; Shiamala Gowri, A. Combined effect of bacteriocin with gold nanoparticles against food spoiling bacteria-an approach for food packaging material preparation. Int. Food Res. J. 2013, 20, 1909–1912. [Google Scholar]
- Rizwan, M.; Hussain, M.; Muhammad; Rauf, A.; Zafar, M.N.; Mabkhot, Y.N.; Maalik, A. Green synthesis and antimicrobial evaluation of silver nanoparticles mediated by leaf extract of Syzygium cumini against poultry pathogens. Micro Nano Lett. 2020, 15, 600–605. [Google Scholar] [CrossRef]
- Rizwan, M.; Amin, S.; Malikovna, B.K.; Rauf, A.; Siddique, M.; Ullah, K.; Bawazeer, S.; Farooq, U.; Mabkhot, Y.N.; Ramadan, M.F. Green synthesis and antimicrobial potential of silver nanoparticles with Boerhavia procumbens extract. J. Pure Appl. Microbiol. 2020, 14, 1437–1451. [Google Scholar] [CrossRef]
- Ekennia, A.; Uduagwu, D.; Olowu, O.; Nwanji, O.; Oje, O.; Daniel, B.; Mgbii, S.; Emma-Uba, C. Biosynthesis of zinc oxide nanoparticles using leaf extracts of Alchornea laxiflora and its tyrosinase inhibition and catalytic studies. Micron 2020, 141, 102964. [Google Scholar] [CrossRef]
- Tian, H.; Ghorbanpour, M.; Kariman, K. Manganese oxide nanoparticle-induced changes in growth, redox reactions and elicitation of antioxidant metabolites in deadly nightshade (Atropa belladonna L.). Ind. Crop. Prod. 2018, 126, 403–414. [Google Scholar] [CrossRef]
- Bukar, A.; Mukhtar, M.D.; Adamu, S. Isolation and identification of postharvest spoilage fungi associated with sweet oranges (Citrus sinensis) traded in kano metropolis. Bayero J. Pure Appl. Sci. 2010, 2, 122–124. [Google Scholar] [CrossRef] [Green Version]
- Dashwood, E.P.; Fox, R.A.; Perry, D.A. Effect of inoculum source on root and tuber infection by potato blemish disease fungi. Plant Pathol. 1992, 41, 215–223. [Google Scholar] [CrossRef]
- Balali, G.R.; Neate, S.M.; Scott, E.S.; Whisson, D.L.; Wicks, T.J. Anastomosis group and pathogenicity of isolates of Rhizoctonia solani from potato crops in South Australia. Plant Pathol. 1995, 44, 1050–1057. [Google Scholar] [CrossRef]
- Fawole, M.O.; Oso, B.A. Laboratory Manual of Microbiology; Spectrum Book Ltd.: Ibadan, Nigeria, 1988; pp. 22–45. [Google Scholar]
- Mailafia, S.; Okoh, H.O.G.R.; Olabode, K.; Osanupin, R. Isolation and identification of fungi associated with spoilt fruits vended in Gwagwalada market, Abuja, Nigeria. Vet. World 2017, 10, 393. [Google Scholar] [CrossRef] [PubMed] [Green Version]
- Rizwan, H.M.; Zhimin, L.; Harsonowati, W.; Waheed, A.; Qiang, Y.; Yousef, A.F.; Munir, N.; Wei, X.; Scholz, S.S.; Reichelt, M.; et al. Identification of fungal pathogens to control postharvest passion fruit (Passiflora edulis) decays and multi-omics comparative pathway analysis reveals purple is more resistant to pathogens than a yellow cultivar. J. Fungi 2021, 7, 879. [Google Scholar] [CrossRef] [PubMed]
- Domsch, K.H.; Gams, W.; Anderson, T.-H. Compendium of Soil Fungi; Academic Press (London) Ltd.: London, UK, 1982. [Google Scholar] [CrossRef]
- Manogar, P. Studies on the Efficient Dual Performance of Lyngbya Majuscula Extract with Manganese Dioxide Nanoparticles in Photodegradation and Antimicrobial Activity. 2021. Available online: https://assets.researchsquare.com/files/rs-1102629/v1/88518079-8f06-4541-b77e-b7ca039a2884.pdf?c=1638287458 (accessed on 14 April 2022).

Publisher’s Note: MDPI stays neutral with regard to jurisdictional claims in published maps and institutional affiliations. |
© 2022 by the authors. Licensee MDPI, Basel, Switzerland. This article is an open access article distributed under the terms and conditions of the Creative Commons Attribution (CC BY) license (https://creativecommons.org/licenses/by/4.0/).
Share and Cite
Faisal, S.; Khan, S.; Abdullah; Zafar, S.; Rizwan, M.; Ali, M.; Ullah, R.; Albadrani, G.M.; Mohamed, H.R.H.; Akbar, F. Fagonia cretica-Mediated Synthesis of Manganese Oxide (MnO2) Nanomaterials Their Characterization and Evaluation of Their Bio-Catalytic and Enzyme Inhibition Potential for Maintaining Flavor and Texture in Apples. Catalysts 2022, 12, 558. https://doi.org/10.3390/catal12050558
Faisal S, Khan S, Abdullah, Zafar S, Rizwan M, Ali M, Ullah R, Albadrani GM, Mohamed HRH, Akbar F. Fagonia cretica-Mediated Synthesis of Manganese Oxide (MnO2) Nanomaterials Their Characterization and Evaluation of Their Bio-Catalytic and Enzyme Inhibition Potential for Maintaining Flavor and Texture in Apples. Catalysts. 2022; 12(5):558. https://doi.org/10.3390/catal12050558
Chicago/Turabian StyleFaisal, Shah, Shahzar Khan, Abdullah, Sania Zafar, Muhammad Rizwan, Muhammad Ali, Riaz Ullah, Ghadeer M. Albadrani, Hanan R. H. Mohamed, and Fazal Akbar. 2022. "Fagonia cretica-Mediated Synthesis of Manganese Oxide (MnO2) Nanomaterials Their Characterization and Evaluation of Their Bio-Catalytic and Enzyme Inhibition Potential for Maintaining Flavor and Texture in Apples" Catalysts 12, no. 5: 558. https://doi.org/10.3390/catal12050558
APA StyleFaisal, S., Khan, S., Abdullah, Zafar, S., Rizwan, M., Ali, M., Ullah, R., Albadrani, G. M., Mohamed, H. R. H., & Akbar, F. (2022). Fagonia cretica-Mediated Synthesis of Manganese Oxide (MnO2) Nanomaterials Their Characterization and Evaluation of Their Bio-Catalytic and Enzyme Inhibition Potential for Maintaining Flavor and Texture in Apples. Catalysts, 12(5), 558. https://doi.org/10.3390/catal12050558

